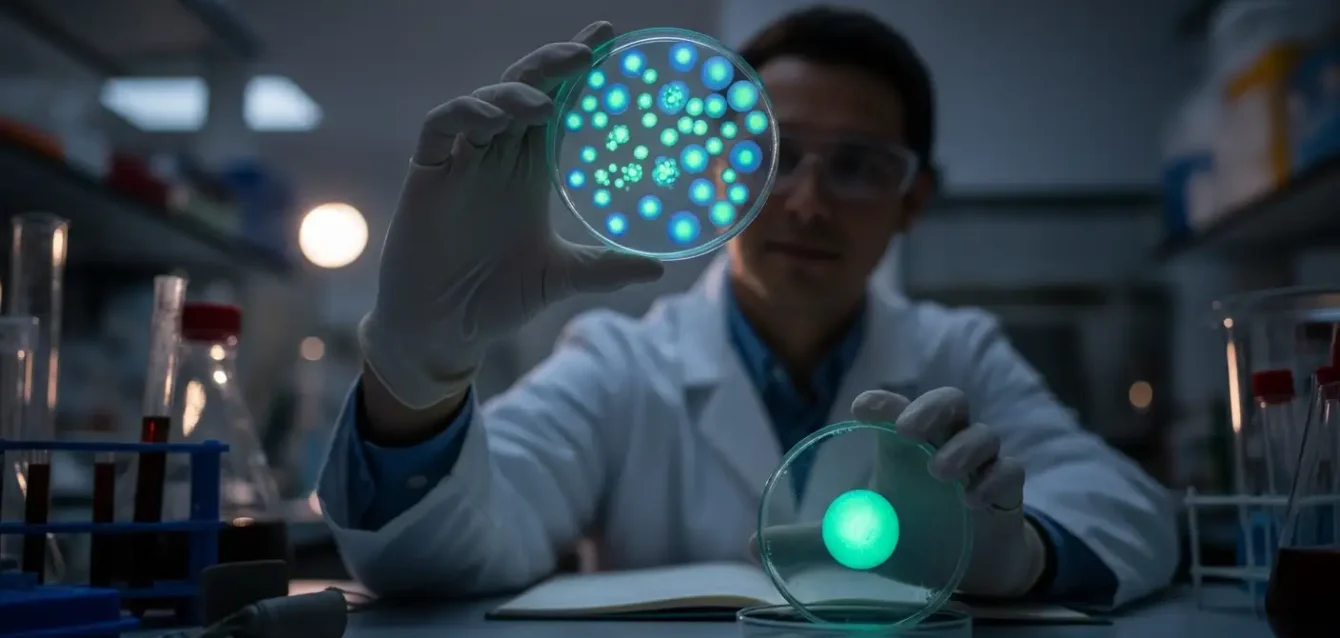
Google_AI_Studio_2025-12-18T03_44_06.263Z Google_AI_Studio_2025-12-18T03_44_06.263Z

GPT-5.2 aprobó el 77% de problemas tipo Olimpiada pero apenas el 25% de tareas de investigación real, revelando una brecha enorme entre resolver ejercicios estructurados y enfrentar desafíos científicos abiertos. Mientras tanto, el mismo modelo mejoró un protocolo de clonación de ADN 79 veces en laboratorio real, demostrando que la IA puede optimizar procedimientos experimentales…
FrontierScience: el test que revela cuán lejos está la IA de ser científica real
Publicaciones Recientes
Peatones impredecibles: la IA que los anticipa
<p>OmniPredict: la IA que intenta anticipar tu próximo paso (sin telepatía) Un modelo multimodal, del tipo que hoy ya
Consultaste síntomas en ChatGPT creyendo que era privado: esta extensión vendió todo
<p>Urban VPN, una extensión destacada por Google que prometía proteger tu privacidad, estuvo durante meses espiando y


